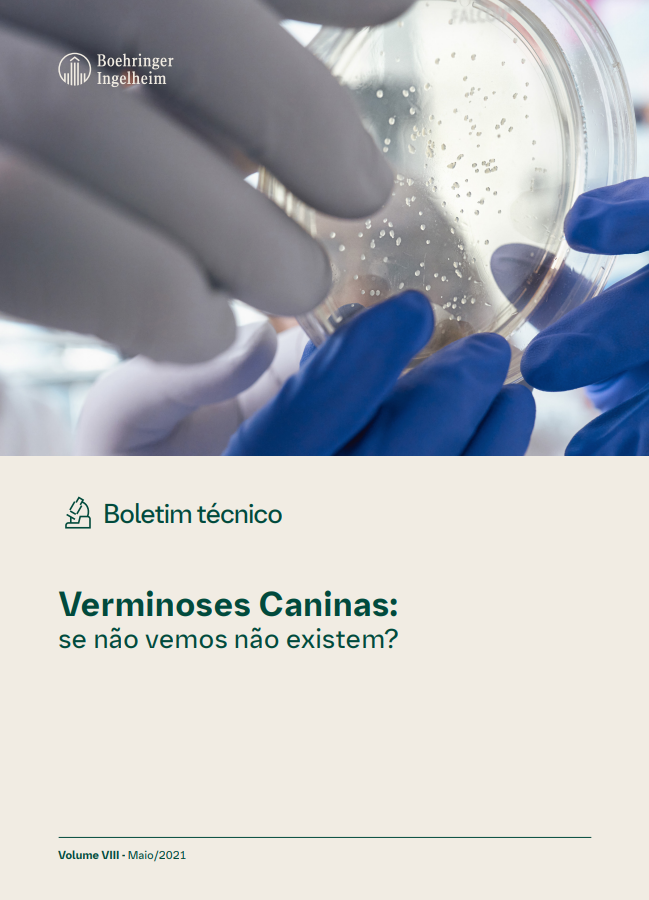

NexGard Spectra®
Afoxolaner e Milbemicina oxima
NexGard Spectra® tem como princípios ativos o Afoxolaner e a Milbemicina oxima, moléculas que eliminam pulgas, carrapatos, ácaros e vermes nematódeos, através da ação no sistema nervoso dos parasitas. Em estudo comparativo com outros produtos da mesma categoria, o NexGard Spectra®, assim como o NexGard®, foi preferido pelos cães, comprovando que a palatabilidade da linha NexGard® continua excelente. NexGard Spectra® tem segurança comprovada: não tem efeito cumulativo, podendo ser administrado em todas as raças de cães, inclusive em cães da raça Collies e raças correlatas. Em estudos de segurança em cães a partir de 8 semanas de idade, com doses até 5x maiores que a terapêutica, não foram observados eventos adversos. NexGard Spectra® pode ser administrado com alimento ou em jejum e deve ser utilizado mensalmente.
Indicação para cães adultos ou filhotes a partir de 2 meses e 2 kilos de peso.